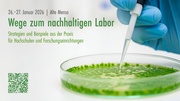
nächste Seite →

Datei:Blitzlicht-Session 3 Göttingen.pdf
Aus DG HochN-Wiki
Größe der JPG-Vorschau dieser PDF-Datei: 800 × 450 Pixel.
Originaldatei (2.000 × 1.125 Pixel, Dateigröße: 1,61 MB, MIME-Typ: application/pdf, 11 Seiten)
Green Lab-Pilotprojekt und -Portal
Dateiversionen
Klicke auf einen Zeitpunkt, um diese Version zu laden.
| Version vom | Vorschaubild | Maße | Benutzer | Kommentar | |
|---|---|---|---|---|---|
| aktuell | 13:47, 2. Mär. 2026 | 2.000 × 1.125, 11 Seiten (1,61 MB) | CarlaWe (Diskussion | Beiträge) |
Du kannst diese Datei nicht überschreiben.
Dateiverwendung
Die folgende Seite verwendet diese Datei: